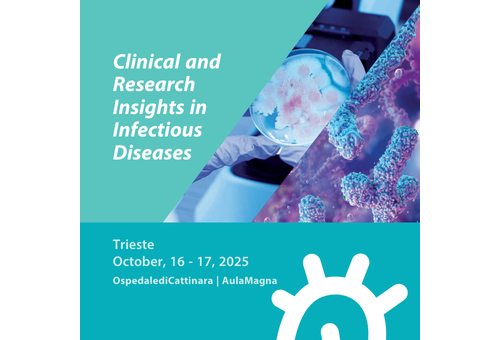
Clinical and Research Insight in Infectious Diseases

Seminari, Corsi e Convegni

Programma evento M&PD ESC Congress 28-29 11 Trieste
A Trieste il Meeting annuale del Working Group della Società Europea di Cardiologia sulle Malattie del Miocardio e del Pericardio.

Inaugurazione murales progetto "Streer Art"
Lunedì 17 novembre dalle 12.00 Via dell’Infanzia 5, Staranzano

La ricerca e la cura: update 2025
Si rinnova con l’UPDATE 2025 l’occasione di unire competenza e innovazione nei vari ambiti professionali che concorrono al percorso diagnostico-terapeutico per i tumori dell’apparato gastrointestinale.

Management infermieristico e altre professioni del paziente multimorbido
24 ottobre 2025 Porto vecchio - magazzino 27


Congresso Regionale SIGG
Sezione Friuli Venezia Giulia Sabato 18 ottobre 2025 Auditorium Seminario Vescovile - Trieste

Congresso Nazionale Società Italiana di Chirurgia d'Urgenza e Trauma Trieste
17-18ottobre 2025 Trieste
Clinical and Research Insight in Infectious Diseases
L'evento "Approfondimenti clinici e di ricerca sulle malattie infettive" riunisce esperti di spicco per presentare progressi all'avanguardia nella diagnostica, nella gestione e nelle strategie terapeutiche delle malattie infettive.


Vivere con la Cardiomiopatia - Evento Introduttivo alla Giornata Mondiale del Cuore
martedì 23 settembre 2025 - ore 16:30 - 17:30 Aula Foreman Casali - Polo Cardiologico Ospedale Cattinara